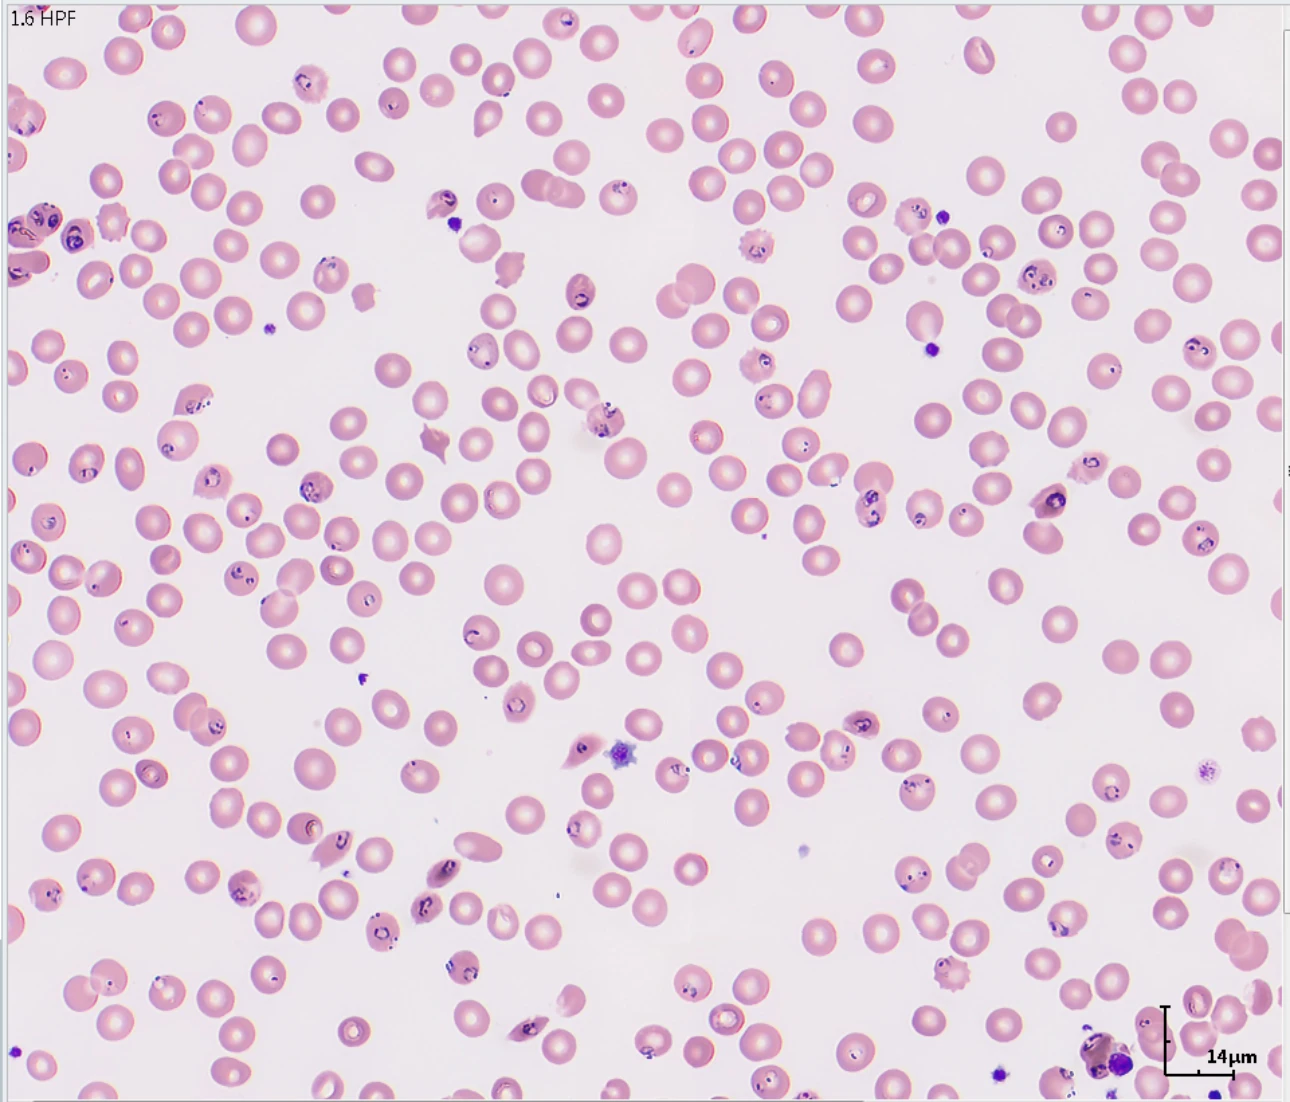
thrombocytopenia-fig3

Hemabook Chapter 24: What can you discover in the re-examination triggered by thrombocytopenia?
2024-07-22

Case Study at A Regional Medical Laboratory Center in Shenzhen
On February 16, during the Spring Festival in China, the laboratory was bustling with activity. Amidst the routine examination of numerous blood smears, a CBC sample arrived urgently from the emergency channel. The patient exhibited symptoms of fever and confusion. Immediate testing of the sample revealed the following CBC results: WBC: 20.77×109/L, RBC: 2.24×1012/L, HGB: 69g/L, and PLT: 44×109/L. Additionally, the hematology analyzer displayed abnormal scattergram data and alarm messages, indicating the possible presence of immature granulocytes, abnormal lymphocytes, a left shift, and platelet aggregation. The low platelet count in the patient triggered a mandatory re-examination according to departmental rules. Consequently, the team conducted microscopic examinations of the blood smears while simultaneously reviewing the patient's emergency medical records.


Chief Complaint
A 37-year-old female patient presented with a four-day history of high fever, accompanied by an hour of unconsciousness. She experienced recurrent high fevers along with occasional cough and sputum production. She took oral antipyretics of unknown type. After being unresponsive for nearly an hour, her family promptly called emergency services, and she was transported to the hospital. Physical examination findings: T:40℃. CP: 147 times/min, BP: 125/69 mmHg, SpO2: 95 %, pupils: equal in size and round, D3.0 mm, sluggishly responsive to light, coarse breath sounds were detected in both lungs without rales. The patient was uncooperative during the abdominal examination, and no pathological signs were elicited in the extremities.
Re-examination Considerations
The patient presented with high fever, confusion, moderate anemia, and a low platelet count. What could be the underlying cause of these symptoms? A blood smear was prepared and analyzed using a morphology analyzer. Upon examination of the blood smears, neutrophils were observed engulfing unknown pigments in the WBC classification region. Furthermore, a careful examination of the RBCs revealed a large number of ring-like structures in mature RBCs. Could these be indicative of a significant presence of Plasmodium ring forms?

With this in mind, a re-examination was conducted using the Malaria Test Kit (Colloidal Gold). Three red lines became visible in the test area. According to the reagent instructions, this confirmed a positive T1+2 result, indicating the presence of Plasmodium falciparum. However, the possibility of a mixed infection with the other three types of malaria could not be ruled out. The clinical department was immediately informed, and the case was reported to the hospital's prevention and control department. New samples were then collected and sent to the Centers for Disease Control and Prevention (CDC) for confirmation of the parasite species. Subsequent results confirmed the presence of Plasmodium falciparum.

Hints
In this case, the patient's blood test underwent morphological re-examination due to violations of re-examination rules, triggered by moderate anemia, a low PLT count, and an abnormal DIFF scattergram (the initial PLT count result was <80×109/L, along with an abnormal scattergram). Despite the absence of a request for Plasmodium testing by clinicians, the diagnosis could have easily been missed if smear re-examination had not been conducted.
More Information
The development of Plasmodia in the human body is typically divided into two stages: the liver stage (pre-erythrocytic stage) and the blood stage (erythrocytic stage) [1-2].
Pre-erythrocytic stage
When an infectious female Anopheles mosquito bites a human, sporozoites enter the bloodstream via the mosquito's saliva. These sporozoites then invade hepatocytes, where they multiply and mature into schizonts, eventually transforming into merozoites. The proliferation time of merozoites varies: 5 to 6 days for Plasmodium falciparum, 8 days for Plasmodium vivax, 9 days for Plasmodium ovale, and 11 to 12 days for Plasmodium malariae. Once the schizonts mature, they release merozoites from the infected hepatocytes into the bloodstream, where they invade red blood cells (RBCs).
For Plasmodium vivax and Plasmodium ovale, some tachysporozoites mature into merozoites through the schizont proliferation process and enter the bloodstream, while others enter a dormant state as hypnozoites or bradysporozoites. These dormant forms can reactivate and mature into schizonts after a period ranging from one month to one year, leading to relapses of vivax malaria and ovale malaria. In contrast, Plasmodium falciparum and Plasmodium malariae do not form hypnozoites or bradysporozoites, so falciparum malaria and quartan malaria do not relapse.
Erythrocytic stage
During the erythrocytic stage, the Plasmodium schizonts that invade RBCs continue to proliferate, forming small trophozoites (ring forms), large trophozoites, and schizonts. When the RBCs containing mature schizonts disintegrate, clinical symptoms are triggered. The released schizonts then invade other RBCs, repeating the erythrocytic proliferation process and causing recurrent clinical symptoms. After 3 to 6 generations of schizont proliferation, some Plasmodia develop into gametocytes, becoming contagious. This stage is considered the optimal phase for detection of Plasmodia.

Summary
Although China was certified malaria-free in June 2021, cases of imported malaria continue to occur over an extended period. The patient in this case had a history of travel to Africa before the onset of the disease. Upon the initial manifestation of Falciparum malaria, the patient's blood mainly contained small trophozoites (ring forms), which are characterized by their diminutive size and varied shapes, making differentiation challenging. However, thrombocytopenia is present in patients with various diseases. Strict re-examination, careful observation and analysis of the scattergram characteristics, and mastering and flexibly applying knowledge of cell morphology can aid in screening for Plasmodium infection.

We extend our gratitude to the authors Wang Cheng and Liu Xiaoliu, as well as their supervisor Luo Yanping, from the Medical Laboratory Center of Luohu Hospital Group, Shenzhen, China
References:
[1]Liu Wenxiong, Qiu Minghao, Mao Yuanke, et al. Application of blood cell histogram combined with blood smear analysis in the diagnosis of malaria[J]. Journal of Molecular Diagnosis and Therapy. 2023,15(09):1587-1590.
[2]Li Lanjuan, Zhang Wenhong, et al. Malaria diagnosis and treatment guidelines [J]. Chinese Journal of Parasitology and Parasitic Diseases. 2022, 40(04):419-427.
[3]Li J, Saidi AM, Seydel K, Lillehoj PB. Rapid diagnosis and prognosis of malaria infection using a microfluidic point-of-care immunoassay. Biosens Bioelectron. 2024 Apr 15;250:116091.

